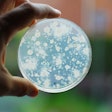
bacteria culture growing on agar plate

bioMérieux
The bioMérieux GENE-UP ENVIROPRO simultaneously detects both Salmonella and Listeria from environmental swabbing, including PCR confirmation. The solution provides cost savings, laboratory waste reduction and a streamlined workflow to empower rapid and effective quality decisions.
With GENE-UP ENVIROPRO, users can test environments for both Salmonella and Listeria through one swab, one enrichment and one sample prep, improving overall sampling efficiencies and sustainability.